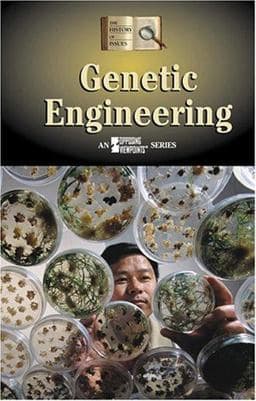
9780737719079

Genetic Engineering
by Helen Cothran (Editor)Bonnie Szumski (Contribution by)Bruce Glassman (Contribution by)Mikko Canini (Editor)
Format: Paperback
ISBN13: 9780737719079
Paperback|9780737719079
✨ Featured Offer
Used, Very Good
$43.04
List Price: $39.70
🚚
See all 2 offers from $43.04 FREE standard delivery by: 03 Apr 2026
Overview
Each anthology in the series contains a wide range of primary documents -- including speeches, court cases, personal reflections, and newspaper accounts -- that present controversies from previous eras and the present.
| ISBN-13 | 9780737719079 |
|---|---|
| ISBN-10 | 0737719079 |
| Weight | 0.85 Pounds |
| Dimensions | 5.50 x 0.75 x 8.50 In |
| List Price | $39.70 |
| Format | Paperback |
|---|---|
| Language | English |
| Pages | 240 pages |
| Publisher | Greenhaven Press |
| Published On | 2004-09-10 |
View All Offers
Sort by:
Price
Condition
Seller
Seller Comments
Price
✨ Used, Very Good
Seller details
The Book Cellar
Nashua, NH, USA
Size: 5x0x8; Great used condition. Ex-library copy A portion of your purchase of this book will be...
Free delivery by: 03 Apr 2026
Used, Good
Seller details
Bonita
Santa Clarita, CA, USA
Access codes and supplements are not guaranteed with used items. May be an ex-library book.
Free delivery by: 03 Apr 2026